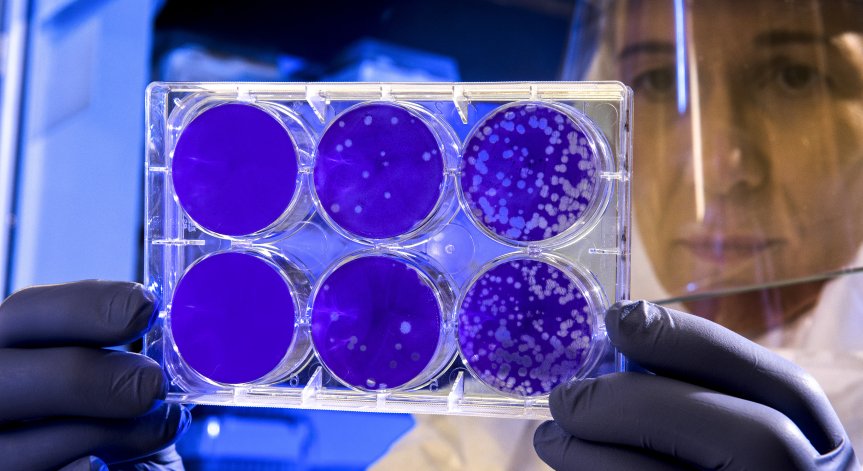
Трябва да сме предпазливи с Омикрон, но без паника

Новият вариант на Ковид-19 Омикрон скорострелно достига до все повече страни.
"Хората не трябва да се плашат от Омикрон. Ние научихме много от случилото се с Делта, а там не реагирахме достатъчно бързо. Забавихме се и Делта се разпространи по целия свят преди да го проучим и да се научим как да се защитим", заяви Нанси Бакстър, ректор на Melbourne School of Population and Global Health.
Тя уточни, че Световната здравна организация е реагирала много адекватно при появата на Омикрон.
"Винаги е добре да сме предпазливи. Не мисля, че хората трябва да изпадат в паника. Това няма да ни върне към март 2020 г., не това очакваме. Отбелязахме голям напредък. До момента никой не е казал, че ваксините нямат никакъв ефект върху Омикрон. Въпросът е доколко се понижава ефектът от ваксината, ако въобще го понижава. Това е даде насоки дали се налага нов бустер, който да е специфичен за новия вариант", уточни Бакстър, цитирана от bloombergtv.bg.
За Делта това се наложи. Наблюденията в Южна Африка показват, че Омикрон се предава по-лесно. Но процентът на случаи на Делта в страната е бил много нисък. Предстои да се разбере дали новият вариант се конкурира с Делта в разпространението.
Снимка: Bloomberg.com
Харесайте страницата ни във Facebook ТУК

Вдовецът на Тина Търнър си има нова приятелка, влюбен е в 60-годишна американка
Вдовецът на Тина Търнър си има нова приятелка, влюбен е в 60-годишна американка  Магическото мислене на САЩ за Украйна
Магическото мислене на САЩ за Украйна  Защо Джордж Клуни се ядосал на Брад Пит в далечната 1991 г.?
Защо Джордж Клуни се ядосал на Брад Пит в далечната 1991 г.?  Кейт Мидълтън впечатли с най-голямата си тиара досега
Кейт Мидълтън впечатли с най-голямата си тиара досега 
 Хранителен режим при Хашимото
Хранителен режим при Хашимото  Стартират нови национални програми за скрининг на колоректален и цервикален рак
Стартират нови национални програми за скрининг на колоректален и цервикален рак  Защо корейското кимчи е полезно за имунната система?
Защо корейското кимчи е полезно за имунната система?  Инфекция с Campylobacter при деца – как да я разпознаем?
Инфекция с Campylobacter при деца – как да я разпознаем? 
 продава, Къща, 688 m2 Бургас област, гр.Созопол, 990000 EUR
продава, Къща, 688 m2 Бургас област, гр.Созопол, 990000 EUR  продава, Офис, 36 m2 София, Суха Река, 96000 EUR
продава, Офис, 36 m2 София, Суха Река, 96000 EUR  продава, Двустаен апартамент, 47 m2 София, Център, 124000 EUR
продава, Двустаен апартамент, 47 m2 София, Център, 124000 EUR  дава под наем, Тристаен апартамент, 130 m2 София, Манастирски ливади Изток, 1500 EUR
дава под наем, Тристаен апартамент, 130 m2 София, Манастирски ливади Изток, 1500 EUR  продава, Гараж, паркомясто, 47 m2 София, Суха Река, 70000 EUR
продава, Гараж, паркомясто, 47 m2 София, Суха Река, 70000 EUR 
 Съоснователят на Neuralink стартира проект, който може да промени човешката еволюция
Съоснователят на Neuralink стартира проект, който може да промени човешката еволюция  Роботът Optimus е усвоил бягането, движейки се почти като човек
Роботът Optimus е усвоил бягането, движейки се почти като човек  Открита е уязвимост в механизма за възстановяване на ДНК на раковите клетки
Открита е уязвимост в механизма за възстановяване на ДНК на раковите клетки  Blue Origin представи проектиран с AI източник на енергия за Луната
Blue Origin представи проектиран с AI източник на енергия за Луната 
 Оперираха Здравко от "Ритон"
Оперираха Здравко от "Ритон"  Изтеглиха жребия за световното по футбол през 2026 г. Вижте всички групи
Изтеглиха жребия за световното по футбол през 2026 г. Вижте всички групи  Спасители във Варна извадиха немска овчарка от 25-метров кладенец
Спасители във Варна извадиха немска овчарка от 25-метров кладенец  Проблемите с водата в Аврен продължават
Проблемите с водата в Аврен продължават  През 2024 г. България e сред най-засегнатите държави в ЕС от горски пожари
През 2024 г. България e сред най-засегнатите държави в ЕС от горски пожари 
 Кадър на деня за 5 декември
Кадър на деня за 5 декември  S&P 500 отчита четвърти пореден ден на ръст и се повишава с 0,4% за седмицата
S&P 500 отчита четвърти пореден ден на ръст и се повишава с 0,4% за седмицата  Всяко второ предприятие у нас разполага със собствен уебсайт
Всяко второ предприятие у нас разполага със собствен уебсайт  Гръцкият парламент одобри покупката на ракетни системи за 650 млн. евро от Израел
Гръцкият парламент одобри покупката на ракетни системи за 650 млн. евро от Израел 





